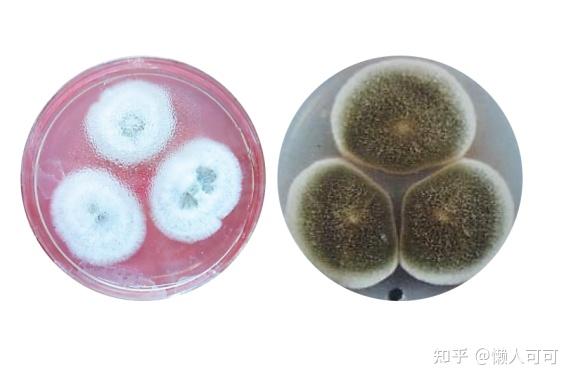
脚气是什么你认识真菌吗

显微镜下的脚气真菌

脚气可没你想的那么简单
图片尺寸700x474
造成脚气的真菌,如果放在培养皿上培养,会变成蘑菇或肉眼可见的东西吗
图片尺寸720x898
显微镜下真菌菌丝,孢子
图片尺寸682x512
导致脚气和灰指甲的小坏蛋每晚都在悄悄吃你
图片尺寸1080x709
这取决于角度——当研究人员将导致瘙痒感染的真菌放在显微镜下观察时
图片尺寸553x422
观察脚气真菌 显微镜倍数要多大
图片尺寸744x992
关于猫藓人类手足癣脚气的细菌真菌的一些微生物知识
图片尺寸720x540
引起脚气的真菌叫皮肤癣菌, 是一种喜欢生活在皮肤角质层中的真菌.
图片尺寸640x853
窝状角质松解症浸渍糜烂型足癣癣菌疹
图片尺寸3328x1872
脚气真菌.这种真菌会导致条件称为脚气
图片尺寸450x335
痒痒痒,撕撕撕,这个折磨人的病怎样才能被根治?_真菌
图片尺寸1080x1439
《8种致病真菌在5种材料上的存活时间研究实验》这是显微镜下的真菌
图片尺寸1080x1342
同事脚臭才发现口罩忘记带!
图片尺寸280x208
脚气灰指甲股癣和体癣都特别痒这里都有
图片尺寸960x889
上海宁为啥老得香港脚
图片尺寸720x516
(1)易得手癣真菌的生命力十分顽强.
图片尺寸2667x2000
生活小常识之脚气 - 季节 - 季节
图片尺寸300x200
真菌感染引起的足癣种类多,症状也不同,及时治疗是关键!
图片尺寸640x427
脚气是什么你认识真菌吗
图片尺寸573x381
"脚气"真菌怎么才能根治?3个人人实用的方法,彻底治好不复发
图片尺寸1200x800